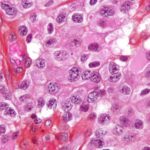
Oligodendroglioma1 high mag1 e1414718034748 أورام المخ المختلفة تنبع من ذات الخلايا مجلة نقطة العلمية

البروتين بار (ألواح الطاقة) ليست عظيمة فقط لمن يحاولون تحسين أدائهم الرياضي ومستوى تحملهم، أو لهؤلاء الذين يريدون الحصول على كتلة أكبر من العضلات، لكنها أيضاً اختيار لهؤلاء الناس الذين ليس لديهم وقت لتناول وجباتهم والذين يريدون وجبة سريعة مغذية ولذيذة في نفس الوقت، لكن من المهم جداً أن تلتفت إلى المكونات المكتوبة على الغلاف قبل أن تتناولها، فصحيح أن بعضها تستطيع بناء عضلاتك لكن البعض الآخر يمكنه أن يهدمها، وصحيح أنها صحية جداً لكن أنواعاً أخرى قد تكون مليئة بالزيوت المهدرجة والمواد الحافظة والسكر والكثير من المواد الكيميائية الأخرى والإضافات.
إليك 6 عناصر عليك أن تبحث عنها في جدول المكونات قبل أن تشتري البروتين بار (ألواح الطاقة):
1-شراب فركتوز الذرة
شراب فركتوز الذرة هو أحد أكثر العناصر المحلّاة استخداماً في البروتين بار وهذا مفهوم بالطبع بسبب رخص ثمن إنتاجه وانتشاره في أنحاء العالم، لكن له آثاراً صحية شديدة إذا تم استخدامه على فترات طويلة فيجب أن ينتبه إليها أولئك الذين يستهلكون البروتين بار لفترات طويلة. وقد ذهب البعض لدرجة مقارنته بالسجائر من حيث الضرر، فهذا المكون ليس موجوداً فقط في البروتين بار بل إنه موجود أيضاً في معظم المشروبات المحلّاة المتوافرة في السوق والمشروبات الغازية والفواكه المعلبة والسلع المخبوزة ومنتجات الألبان أيضاً.
2-زيت بذور النخيل المجزأ
تجزئ الزيت يعتبر غاية في الضرر أياً كان نوعه وعليك أن تحذر منه، وهو منتشر جداً في البروتين بار، فعملية التجزيء تحدث عبر تسخين الزيت بشدة ثم تبريده حتى يتكسر إلى أجزاء، ثم يمر عبر فلتر لكن مع ذلك، يبقى مليئاً بالدهون المشبعة التي تكون البروتين الدهني LDL أو ما يسمى بالكوليسترول السيء الذي يترسب داخل شرايين القلب والدماغ وأجزاء أخرى من الجسم مسبباً ذبحات صدرية أو سكتات دماغية، وهناك الكثير من البدائل لهذا الزيت مثل زيت ثمرة النخيل المضاف إليه فيتامين E والذي يحمي الأحماض الدهنية غير المشبعة من الأكسدة، وبهذا يقلل احتمالات الإصابة بتصلب الشرايين، كما أنه يزيد معدل الأيض في جسدك ويزيد مناعتك في نفس الوقت.
3-سكر الكحول
وهو أيضاً مكوّن منتشر في البروتين بار هذه الأيام، وهو يعرف بالـpolyol وهو نوع من الكربوهيدرات الذي يماثل المكوّنين السابقين خطورة، فالأمعاء الدقيقة تجد صعوبة كبير في تكسيره لأنه مقاوم لعملية التخمر، لذا فإن مشاكله تتراوح من الإسهال إلى استثارة القولون العصبي الذي يعاني منه كثير من الناس هذه الأيام إلى حدوث انتفاخ شديد وغازات وألم مبرّح في البطن، ولحسن الحظ فإن لدينا بدائل كثيرة له أيضاً، ولهذا ينصح خبراء التغذية أو الرياضيون أولئك الذين يريدون زيادة كتلة عضلاتهم بدون التسبب في أي مشاكل صحية لأنفسهم بأنه يمكنهم أن يحاولوا عمل البروتين بار الخاص بهم في المنزل بأنفسهم وبلا جهد يذكر.
4-المحلّيات الصناعية
الكثير من المحلِّيات الصناعية الموجودة في البروتين بار تسبب خللاً في إفراز الأنسولين، وهو الهرمون الذي يقود السكر من الدم إلى داخل الخلايا فتحدث الرغبة الشديدة للإنسان في تناول أي شيء محلّى الطعم. ويفسر باحثون آخرون ما يحدث بأن هذه المواد الصناعية تعطل قدرة جسمك على إنتاج الهرمون المسؤول عن الإحساس بالشبع وعن مستوى السكر في الدم والذي يسمى GLP-1، لذا يصبح الإنسان دون هذا الهرمون أكثر جوعاً حين يستهلك البروتين بار، لذا فبالإضافة لأن المحلّيات الصناعية يمكن أن تجعلك تأكل أكثر وتسمن أكثر، فإنها أيضاً يمكنها أن تتسبب لك بالنوع الثاني من مرض السكري.
5-بروتين مصل اللبن
صحيح أنه في متناول اليد ويمكن الحصول عليه بسهولة لبناء العضلات، فهو السائل الذي ينفصل عن اللبن الرائب أثناء عمل الزبادي، وصحيح أن معظم الرياضيين يتناولونه لكنه إذا ازداد عن اللازم يمثل ضغطاً على الكبد وعلى الكليتين، اللذان يبدآن في ترسيب الكالسيوم بناء على ذلك وبالتالي تكوين الحصوات في الكلية.
6-بروتين الصويا
وهو جيد في مستوياته المعقولة، لكن من المهم أن نعرف أن له آثاراً غاية في الضرر في النساء بالذات، فهو يزيد مستويات الأستروجين لديهم، مما يمكن أن يسبب سرطاني الثدي والرحم.